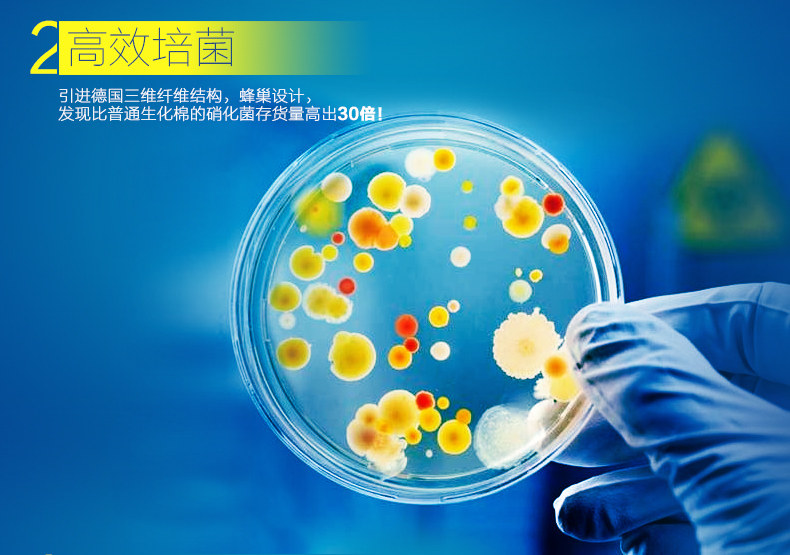

Аквариумный фильтр практичный Биохимический губчатые фильтры мини многослойный
174,24 - 546,97 руб.
Новое поступление
Магазина Shop922257 Store работает с 02.04.2013. его рейтинг составлет 81.32 баллов из 100. В избранное добавили 9371 покупателя. Средний рейтинг торваров продавца 4.3 в продаже представленно 2830 наименований товаров, успешно доставлено 1411 заказов. 182 покупателей оставили отзывы о продавце.
Характеристики
*Текущая стоимость 1 440,07 - 1 695,00 уже могла изменится. Что бы узнать актуальную цену и проверить наличие товара, нажмите "Добавить в корзину"
| Месяц | Минимальная цена | Макс. стоимость | Цена |
|---|---|---|---|
| Mar-18-2026 | 1714.19 руб. | 1800.19 руб. | 1757 руб. |
| Feb-18-2026 | 1699.10 руб. | 1784.1 руб. | 1741.5 руб. |
| Jan-18-2026 | 1426.4 руб. | 1497.72 руб. | 1461.5 руб. |
| Dec-18-2025 | 1670.18 руб. | 1754.84 руб. | 1712 руб. |
| Nov-18-2025 | 1454.45 руб. | 1527.3 руб. | 1490.5 руб. |
| Oct-18-2025 | 1642.21 руб. | 1724.88 руб. | 1683 руб. |
| Sep-18-2025 | 1627.18 руб. | 1708.19 руб. | 1667.5 руб. |
| Aug-18-2025 | 1613.34 руб. | 1694.74 руб. | 1653.5 руб. |
| Jul-18-2025 | 1598.22 руб. | 1678.34 руб. | 1638 руб. |
Описание товара

Смотрите так же другие товары: